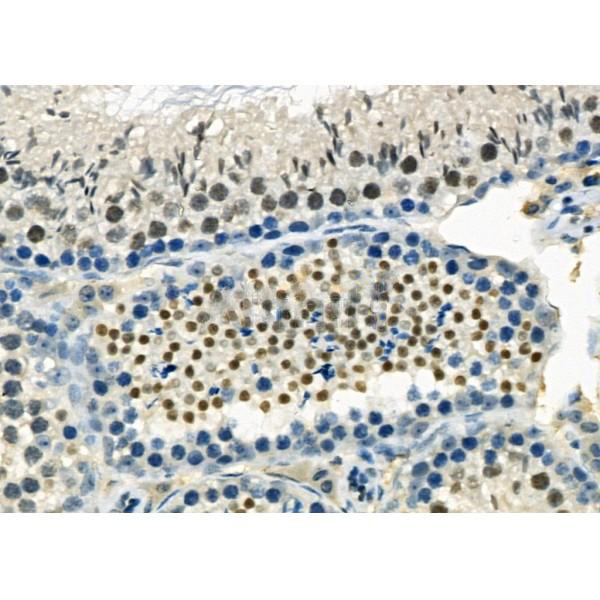

Converts 1-acyl-sn-glycerol-3-phosphate (lysophosphatidic acid or LPA) into 1,2-diacyl-sn-glycerol-3-phosphate (phosphatidic acid or PA) by incorporating an acyl moiety at the sn-2 position of the glycerol backbone. Acts on LPA containing saturated or unsaturated fatty acids C16:0-C20:4 at the sn-1 position using C18:1, C20:4 or C18:2-CoA as the acyl donor. Also acts on lysophosphatidylcholine, lysophosphatidylinositol and lysophosphatidylserine using C18:1 or C20:4-CoA. Has a preference for arachidonoyl-CoA as a donor (By similarity). Has also a modest lysophosphatidylinositol acyltransferase (LPIAT) activity, converts lysophosphatidylinositol (LPI) into phosphatidylinositol (By similarity).
Description
Rabbit polyclonal antibody to AGPAT3
Applications
WB, IF, ICC, IHC
Immunogen
AGPAT3 Antibody detects endogenous levels of total AGPAT3.
Reactivity
Human, Mouse, Rat.
可预测:Pig(100%), Zebrafish(%), Horse(%), Sheep(%), Dog(%), Chicken(%), Xenopus(%)
Molecular weight
40 KD; 43kD(Calculated).
Host species
Rabbit
Ig class
Immunogen-specific rabbit IgG
Purification
Antigen affinity purification
Full name
AGPAT3
Synonyms
1-acyl-sn-glycerol-3-phosphate acyltransferase gamma; 1-acylglycerol-3-phosphate O-acyltransferase 3; 1-AGP acyltransferase 3; 1-AGPAT 3; acyltransferase gamma; AGPAT3; LPAAT-gamma; Lysophosphatidic acid acyltransferase gamma; PLCC_HUMAN; UNQ759/PRO1490;
Storage
Rabbit IgG in phosphate buffered saline , pH 7.4, 150mM NaCl, 0.02% sodium azide and 50% glycerol. Store at -20 °C. Stable for 12 months from date of receipt.
Swissprot
Q9NRZ7




 产品订购:
产品订购:
 渠道电话:
渠道电话: